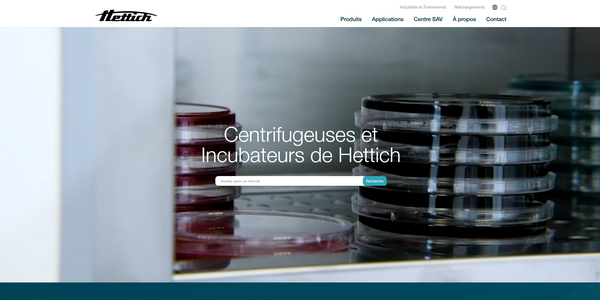

Als international agierender Hersteller von Zentrifugen und Inkubatoren für den medizinischen Bereich bietet Hettich über 120 Jahre Erfahrung und Qualität – dies spiegelt sich jetzt auch in der Online-Präsenz wider.
Für den Relaunch der Website von hettichlab.com haben wir eine Plattform geschaffen, die visuell und technisch neue Maßstäbe setzt. Mit einem responsiven und anwenderfreundlichen Design stellt die Website sicher, dass Informationen zu Produkten und Services für Händler, Tochtergesellschaften und Endkund:innen weltweit schnell und einfach zugänglich sind.
Durch die Zusammenführung der Länderdomains, die Verbesserung der Meta-Angaben und eine neu strukturierte Informationsarchitektur konnten wir die Internationalisierung auf der Website verbessern und zugleich eine klare, SEO-optimierte Nutzerführung umsetzen.
Der Relaunch auf Basis von TYPO3 garantiert eine hohe Performance, übersichtliche Struktur, präzise Nutzerführung und Conversion-Elemente, die Anfragen effektiv fördern.
Hettich
Die Andreas Hettich GmbH steht seit über 120 Jahren für innovative Medizintechnik „Made in Germany“. Mit Sitz in Tuttlingen, entwickelt und produziert das Unternehmen hochwertige Zentrifugen und Inkubatoren für den weltweiten B2B-Markt.
Hettich verbindet dabei höchste Qualitätsstandards mit einer klaren Nutzerorientierung, um den Ansprüchen moderner Labore und Forschungseinrichtungen gerecht zu werden.
Die Marke steht für Präzision und Zuverlässigkeit und findet als Wegbereiter in der Medizintechnik weltweit Anerkennung.
Hettich hatte im Vorfeld des Projekts eine klare Vision: Sie wünschten sich eine neue Website, die technisch und gestalterisch als State-of-the-Art eine herausragende Customer Experience für segmentierte Zielgruppen ermöglicht und so interessierte Nutzer:innen zu qualifizierten Leads transformiert.
Dies stellte besondere Anforderungen an die technische und gestalterische Umsetzung. Die bis dato verwendete Version von TYPO3 war veraltet und die Migration von bestehenden Erweiterungen und PlugIns zu einer neueren Version sehr aufwendig. Es war somit klar, dass das neu entwickelte Webdesign mit responsivem HTML/CSS durch uns umgesetzt und in eine höhere TYPO3-Version integriert werden musste. Zusätzlich galt es, die Inhalte für internationale Tochtergesellschaften zu spiegeln, um eine visuelle Kontinuität zu schaffen.
Die Lösung
Der Relaunch der Website hettichlab.com wurde von uns auf Basis eines strategischen 8-Punkte-Plans mit einem klaren Fokus auf Nutzerführung und technische Exzellenz umgesetzt. Mit einem modernen, responsiven Design auf TYPO3-Basis haben wir klare Strukturen geschaffen, die Orientierung und Effizienz bieten. Das Ergebnis ist eine zukunftssichere, nutzerfreundliche Plattform, die den internationalen Anspruch von Hettich unterstreicht. Die kontinuierliche Weiterentwicklung der Website durch digit.ly gewährleistet zudem, dass die Marke langfristig von einer leistungsstarken und nutzerfreundlichen Plattform profitiert.
- Website Relaunch
- UX-Optimierung
- Verbesserung der Kontaktmöglichkeiten
- Nutzerorientierte Startseite
- Integrierung intuitiver Kontaktformulare
- Pagespeed Optimierung
- Optimierung der Internationalisierung samt Zusammenführung der Länderdomains
- Verbesserungen der Meta-Angaben und der Informationsstruktur
- Kontinuierliche Weiterentwicklung der Website

Unser Ergebnis
Das Ergebnis unserer Zusammenarbeit mit Hettich ist eine auf Leadgenerierung optimierte Webseite mit einem zeitgemäßen UX-Design. Nach dem Relaunch gingen 30 % mehr Anfragen über Kontaktformulare ein und die Seitenimpressionen steigerten sich um 25 % im Monat.
Du willst mit dem nächsten Projekt
digital am Wettbewerb vorbeiziehen?
Wir lieben anspruchsvolle Herausforderungen.

